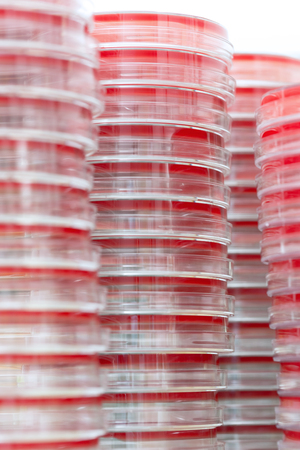
Petry dishes on laboratory tableの写真素材

写真素材 - Petry dishes on laboratory table
キーワード
- background
- blue
- bottle
- capacity
- care
- chemical
- chemistry
- clinical
- color
- crop
- dish
- drug
- equipment
- experiment
- flask
- fluid
- four
- full
- glass
- glassware
- green
- health
- instrument
- isolated
- lab
- laboratory
- liquid
- measurement
- measuring
- medical
- medicine
- ml
- petri
- pharmaceutical
- pharmacy
- reagents
- red
- reflection
- research
- resistant
- science
- scientific
- segment
- size
- temperature
- test
- transparent
- tube
- white
- yellow
類似作品
Hands, plant sc...
Test tubes flas...
petri dishes us...
microbial cultu...
Close-up transp...
Petri dishes wi...
Science laborat...
color liquid in...
Petri dish in a...
Hands, plant sc...
Pipette with dr...
Team of scienti...
Pipette with dr...
Pouring liquid ...
Top view of dif...
top view petri ...
Detail of two p...
laboratory equi...
Group of Petri ...
Plastic Plates ...
A cream spot on...
Production line...
Petri dishes (P...
Microbiology La...
microbial cultu...
Development Of ...
Top view of lab...
Test tubes flas...
Test tubes flas...
Viruses and bac...
Petri dishes wi...
Petri dishes wi...
Test-tubes and ...
Samples contami...
Bottles with gl...
glass petri dis...
Group of scient...
empty petri dis...
Collaboration, ...
pills and medic...
Concept of scie...
Petri dishes wi...
Antiaging cosme...
Background with...
Group of petri ...
Growth of diffe...
Scientific hand...
Close up of lab...
Medical science...